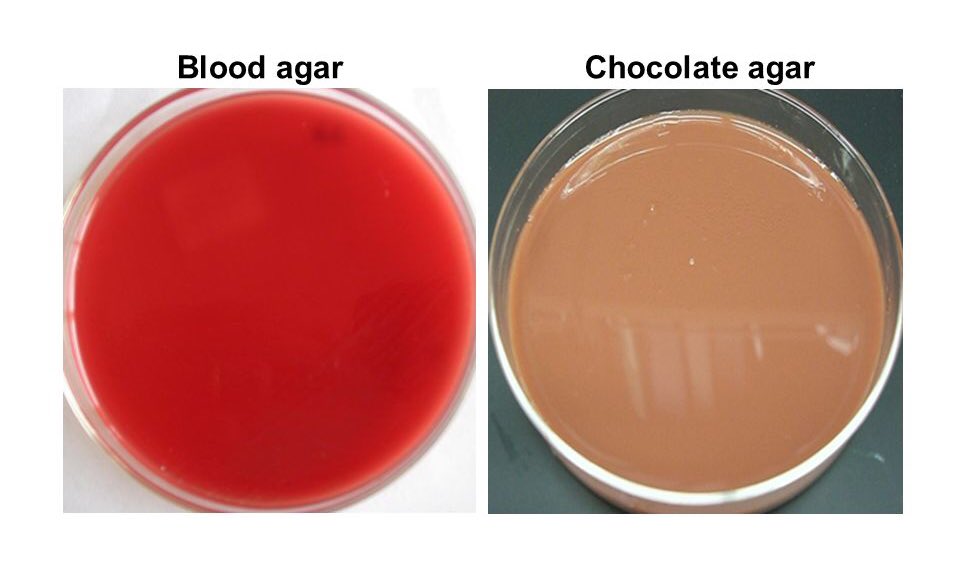
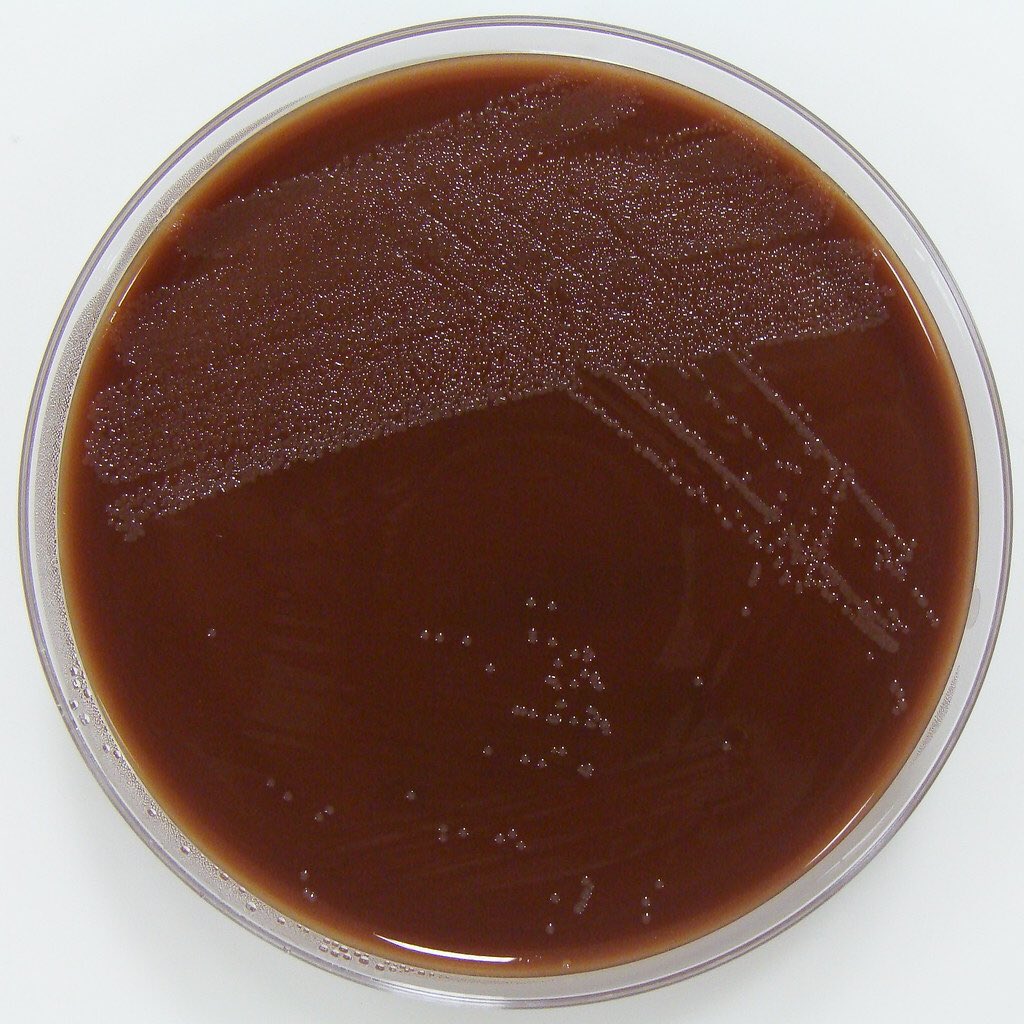

لمعرفة أكثر عن الـBlood Agar :
✨ مكونات الشوكلت أجار :
هي نفسها مكونات البلود أجار بالإضافة الي العوامل ( X و V ) التي خرجت أثناء تكسر خلايا الدم الحمراء.
❗️نكرر الشوكلت أجار لا يحتوي على شكل من أشكال الشوكلاتة و قد تم تسميته بهذا الاسم بسبب شكله و لونه.
هي نفسها مكونات البلود أجار بالإضافة الي العوامل ( X و V ) التي خرجت أثناء تكسر خلايا الدم الحمراء.
❗️نكرر الشوكلت أجار لا يحتوي على شكل من أشكال الشوكلاتة و قد تم تسميته بهذا الاسم بسبب شكله و لونه.
جاري تحميل الاقتراحات...